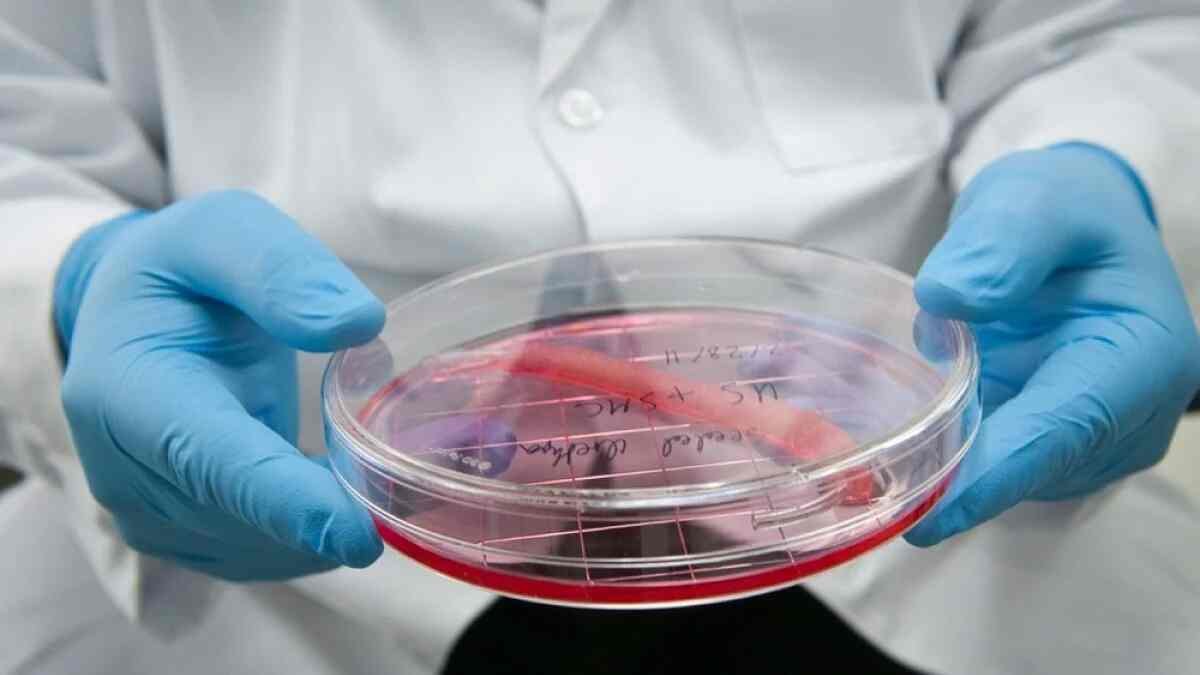

The future of medicine is no longer limited to donors and waiting lists. Lab-grown organs, once considered pure science fiction, are rapidly becoming one of the most groundbreaking developments in global healthcare. In 2026, advances in organoid technology, stem cell engineering, and regenerative medicine are pushing humanity closer to a world where damaged organs can be replaced with custom-built biological alternatives.
At the center of this revolution are organoids, tiny lab-grown structures that mimic real human organs. These miniature versions of the brain, liver, kidneys, and even lungs are created using stem cells and are capable of replicating key biological functions. Scientists are now able to grow organoids that not only resemble human organs structurally but also behave like them at a cellular level, making them powerful tools for both research and treatment.
Recent breakthroughs have significantly improved the complexity of these lab-grown systems. Researchers have successfully developed organoids with their own blood vessel networks, solving one of the biggest challenges in regenerative medicine. This advancement allows organoids to survive longer and function more realistically, bringing them closer to being used in actual transplants. The ability to create vascularized tissues marks a major leap forward, as proper blood flow is essential for any fully functional organ.
One of the most promising developments is in kidney research. Scientists have managed to grow more mature and complex kidney structures in the lab than ever before. These structures, known as kidney organoids, are now being tested in combination with animal organs to evaluate their viability for transplantation. While still in the experimental stage, this progress suggests that lab-grown kidneys could one day become a realistic solution for millions of patients suffering from renal failure.
The implications of these advancements go far beyond transplantation. Lab-grown organs are already transforming drug testing and disease research. Instead of relying on animal testing, scientists can now study human-like organ systems in controlled environments. This not only improves accuracy but also addresses ethical concerns associated with animal experimentation. Organoids are being used to model complex diseases such as cancer, allowing researchers to observe how tumors grow and respond to treatments in real time.
In fact, some biotech companies are taking this concept even further. Recent developments include the creation of full organ systems grown from human cells, designed specifically for drug testing and potentially future transplants. These systems, built without brain function, aim to eliminate ethical concerns while providing scalable biological models for medical research. This approach could dramatically accelerate the development of new medicines and therapies.
Despite the rapid progress, challenges remain. Scientists are still working to overcome issues related to size, durability, and full functionality of lab-grown organs. Creating a complete organ that can integrate seamlessly into the human body requires precise coordination of multiple biological systems, something that is still under development. Additionally, ethical questions surrounding the creation of human-like tissues continue to spark global debate.
However, the urgency of this innovation cannot be overstated. The world faces a severe shortage of donor organs, with only a fraction of patients receiving the transplants they need each year. Lab-grown organs offer a potential solution to this crisis, with the promise of unlimited, personalized organ supply tailored to individual patients.
As research accelerates, the vision of growing fully functional human organs in laboratories is becoming increasingly realistic. What was once a distant dream is now a rapidly advancing field that could redefine modern healthcare. Lab-grown organs are not just a scientific breakthrough but a life-saving innovation that has the potential to eliminate transplant waiting lists and transform how we treat disease in the future.